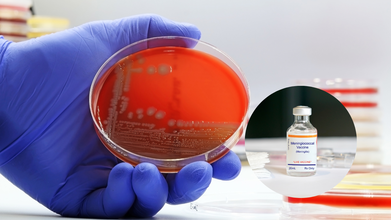

- Health Conditions A-Z
- Health & Wellness
- Nutrition
- Fitness
- Health News
- Ayurveda
- Videos
- Medicine A-Z
- Parenting
Heather Dubrow Warns Of ‘Ozempic Vulva’; What Is This Unique Symptom of Taking Ozempic?

Credits: Canva
Ozempic Vulva: Dr. Terry Dubrow and his wife, Heather Dubrow, recently spoke about a lesser-known side effect of the popular weight-loss drug Ozempic. The reality TV couple revealed on their iHeart podcast ‘Between Us’ that even their four kids were shocked by the conversation.
Ozempic has been gaining attention as a weight-loss medicine, but many users are not aware of certain effects it may have. However, Heather and Terry highlighted one unique change that has started making waves online, the “Ozempic vulva.”
Heather Dubrow Warns of ‘Ozempic Vulva’: What You Need to Know
During the podcast, the couple didn’t hold back. Terry admitted, “We talked about stuff that’s shockingly personal, maybe even a little TMI.” Heather chimed in, noting, “Our kids definitely were not thrilled when we started discussing Ozempic vulva.” Terry, with his medical expertise, explained the reasoning behind it, saying, “Rapid fat loss can reduce estrogen levels, which may lead to less lubrication, irritation, and changes in volume in that area.”
What Is Ozempic Vulva?
“Ozempic vulva” is not a medical term but a trendy phrase describing how some women notice changes in their vulva after taking Ozempic or similar weight-loss medications. These changes are usually linked to rapid weight loss rather than the drug itself. Most commonly, women report that the outer lips of the vulva look less full or appear saggy, and they may experience dryness, irritation, or discomfort.
How Ozempic Works?
Ozempic contains semaglutide, a prescription drug mainly used to manage type 2 diabetes by lowering blood sugar. It mimics a natural hormone called GLP-1, which helps the body release insulin when blood sugar is high, slows digestion, and reduces appetite. Beyond diabetes management, Ozempic has become popular for weight loss, especially among people with obesity or those at risk of heart disease.
According to Prabha Sivaraman, a consultant obstetrician-gynecologist in the UK, as per Healthline, the phenomenon is not directly caused by Ozempic. “Women are seeing the effects of rapid weight loss on soft tissues. The drug doesn’t act on the vulva, vagina, or pelvic floor directly. These changes are simply by products of body composition shifting quickly,” she explains. Rapid fat loss can particularly affect areas like the mons pubis and labia majora, which normally provide volume and shape.
Ozempic Side Effects
While Ozempic vulva is not an official medical side effect, the drug can cause more common issues such as nausea, vomiting, diarrhea, constipation, stomach pain, reduced appetite, or fatigue. Rarely, serious complications like pancreatitis, kidney or gallbladder problems, or severe allergic reactions can occur. Anyone taking Ozempic should do so under medical supervision and report unusual or severe symptoms to their doctor.
Why Does Ozempic Vulva Happen?
Several factors linked to rapid weight loss may contribute:
- Loss of fat and volume: Labia majora contain fatty tissue, and losing fat quickly can make them look thinner or less full.
- Changes in muscle and tissue tone: Weight loss can reduce muscle mass, affecting pelvic support and possibly changing sensation.
- Dehydration and hormonal shifts: Side effects like nausea or diarrhea can cause fluid loss, while lower estrogen from fat loss may reduce natural lubrication.
- Shifts in vaginal microbiome: Rapid changes in diet, digestion, and body chemistry can affect the balance of healthy bacteria, potentially causing irritation, odor, or unusual discharge.
DISCLAIMER: Ozempic vulva is not a direct effect of the drug itself but reflects how rapid weight loss can change the appearance and comfort of the vulva. Staying hydrated and using lubricants can help, and for those concerned, medical advice or cosmetic options are available.
Meningitis May Have Been Contained, Say Experts; Cases Tell A Different Story
Credits: Canva
Meningitis outbreak in Kent University that infected a dozen of people have now further infected more people. The total number as of now is 27, as experts say that incubation period of the bacteria may lead to an increase in number of those who are sick. However, health officials, as per The Guardian report, believe that they have contained the fatal outbreak, with "no cases emerging that are not linked to the original cluster of 20".
Read: UK Meningitis Outbreak: 9-month-old Baby Battles For Life In Intensive Care
The bug that causes the infection has been identified as the known strain of meningitis B and MenB vaccines will be offered to 5,000 students living in the University of Kent halls of residence in Cantebury. While several reports claim that parents are rushing to pharmacies to get their children vaccinated, due to which there is a shortage of the MenB vaccines, health secretary, Wes Streeting has denied any such claims. "There is actually plenty of stock of vaccine supply in the country," he said.
As per the UK Health Security Agency (UKHSA) official, people infected in Kent were the ones who visited a nightclub on 5,6 or 7 March. The officials, including NHS members and county council public health staff who have been tackling the outbreak believe that it has not been passed on to anyone outside the area. "All cases to date are linked to the current outbreak in Kent," said a UKHSA spokesperson, as reported by The Guardian.
Another official involved in the multi-agency response said, "We may have contained it. There are no cases popping up elsewhere that we know of – no cases that we know of outside the cluster – or not yet anyway. We are rolling out a vaccine and antibiotics and tracing contacts. So there’s nothing we’re not doing.”
Quickest-growing Meningitis Outbreak Ever
UKHSA chief executive Susan Hopkins said the outbreak "looks like a super-spreader" event with "ongoing spread" through universities' halls of residence. She added: "There will have been some parties particularly around this, so there will have been lots of social mixing. I can't yet say where the initial infection came from, how it's got into this cohort, and why it's created such an explosive amount of infections."
She further said that in her 35 years working in medicine, healthcare, and hospitals, "This is the most cases I've ever seen in a single weekend with this type of infection". She added: "It is the explosive nature that is unprecedented here - the number of cases in such a short space of time." She also remarked that this was the "quickest-growing outbreak" she has ever seen in her career.
What Is Meningitis?
Meningitis is a serious medical condition that affects the protective membranes covering the brain and spinal cord, the meninges. While fever is not always present, it is usually considered as one of the classic symptoms of meningitis. It is important to know the varied symptoms, causes, and treatments of meningitis for early diagnosis and proper management of the disease.
Meningitis is an infectious illness that brings about inflammation in the meninges. The most common cause of such inflammation is bacterial or viral infections, though other causes are also possible including fungal, parasitic, or non-infectious causes (autoimmune disease, head injury, or brain surgery). Meningitis may be caused by bacterial meningitis, which the Centers for Disease Control and Prevention (CDC) indicates can be so severe and bring about conditions like hearing loss, vision problems, and death if not received on time.
Nearly 90,000 Bottles Of Children's Ibuprofen Recalled As Foreign Particles Were Found

Nearly 90,000 bottles of children's ibuprofen have been recalled nationwide after complaints were made that the medication could contain a foreign substance. The federal health officials complained about the foreign substance due to which Strides Pharma Inc., headquartered in India recalled about 89,592 bottles of Children's Ibuprofen Oral Suspension, noted the US Food and Drug Administration.
The recall happened after reports of a gel-like mass and black particles were found in the products.
FDA Issues Class II Recall Against Children's Ibuprofen

The FDA has issued a Class II recall, which means the use of the affection medication could cause temporary or medically reversible health problems. It also translates to serious harm being considered remote.
FDA has three categories for recall, Class I, Class II, and Class II. Class I recalls usually mean high risk. This could mean that defective products could cause serious health problems or death. Class II is for moderate risk, which has been issued for children's ibuprofen. Class III is for products with low risk. This is for products that are unlikely to cause any adverse health consequence, but they violate FDA labeling or manufacturing regulations.
Read: E. Coli Outbreak Linked To Cheddar Cheese, 7 People In 3 States Affected
India-based Pharmaceutical Company Recalls Nearly 90,000 Bottles Of Ibuprofen
The India headquartered company Strides Pharma was manufacturing the product for Taro Pharmaceuticals USA Inc. and the products were distributed across the United States.
The recalled medication is for the 100-milligram per 5-milliliter oral suspension sold in 4-fluid-ounce bottles. The affected lot numbers are 7261973A and 7261974A, with an expiration date of Jan. 31, 2027. The recall number is D-0390-2026.
Health officials have advised consumers who have the recalled ibuprofen to stop using it. The FDA however has not yet received reports of serious adverse health effects related to the recalls.
Previous Cases Where Indian Drugmakers Distributing To US Recalled Their Products
Certain products were recalled from the US market due to manufacturing relayed issues. These products were by Indian drugmakers Sun Pharmaceutical Industries and Cipla. In an Enforcement Report by the FDA, it noted that the US-based arm of Mumbai-headquartered Sun Pharma has recalled more than 26,000 bottles of generic medicine used to treat dandruff and skin conditions that cause inflammation and itching. Sun Pharma, based in Princeton, New Jersey, recalled 24,624 bottles of Fluocinolone Acetonide Topical Solution after the product failed to meet impurity and degradation standards. The company also initiated Class III recall in US on December 30, 2025.
Cipla recalled over 15,000 syringes from the US market. Headquartered in Warren, New Jersey, the company recalled 15,221 pre-filled syringes of Lanreotide Injection due to the presence of particulate matter. Cipla also initiated a recall of Class II on January 2 of this year.
Kent meningitis outbreak climbs to 27 cases, UK officials warn numbers may continue to rise

Credit: Canva
UK health officials have identified seven more cases of meningitis, as part of the latest outbreak in Kent, taking the total number of cases to 27. They expect the numbers to rise in the coming days.
The UK Health Security Agency noted that it has expanded the Meningitis B vaccine regimen to everyone who has been offered preventative antibiotic treatment as part of this outbreak.
“15 laboratory cases are confirmed and 12 notifications remain under investigation, bringing the total to 27,” the UKHSA said in a statement.
“Currently, cases have been confirmed in students at 4 schools in Kent, as well as one student at a higher education institution in London (who is confirmed to be directly linked to the outbreak),” it added.
Two students -- a 21-year-old student at the University of Kent and a teenage student at a school in the town of Faversham have died in the outbreak.
A 9-month-old baby from Folkestone is reportedly battling for life in the intensive care unit.
Meanwhile, another university in the city confirmed a case of meningitis. The student at Canterbury Christ Church is believed to be a man who was at the nightclub and part of the initial cluster of 20 known cases, who visited Club Chemistry in Canterbury between March 5 and 7.
"We are not in the position yet to say definitively that it's been contained," Dr Anjan Ghosh, Director of Public Health at Kent County Council, told BBC Radio, adding that secondary transmissions needed to be ruled out.
Calling the outbreak “unprecedented”, Health Minister Wes Streeting said: “The number of suspected cases was expected to increase in the coming days because the disease had a seven- to 10-day incubation period”, Reuters reported.
In a typical year, Britain sees about 350 cases, roughly one per day, according to government estimates.
In addition to the approximately 5,000 students who were initially contacted, vaccination will now be extended to everyone who has been offered preventative antibiotic treatment as part of this outbreak, the UKHSA said.
Why The Cases Are Rising
While it remains unclear why the outbreak has been so large, “the large number of cases all originating from what seems to be a single event” is particularly striking, Prof Robin May, the chief scientific officer at the UKHSA, told the BBC Breakfast.
May said that "there might be something about the kind of behaviors that individual people are doing." Another probable reason "is that the bacteria may have evolved to be better at transmitting".
Both the UKHSA and the European Centre for Disease Prevention and Control maintain that the risk of invasive meningococcal disease to the general population in Europe is "very low".
Also read: From Vaping to Worm Attack: 5 Unimaginable Ways to Contract Meningitis
Can The Outbreak Be Prevented?
The UKHSA noted that the key intervention to protect people and halt the spread remains for people to come forward for antibiotic treatment -- effective in preventing contraction and spreading in 90 percent of cases.
In addition, a targeted MenB vaccination program is also being introduced for longer-term protection.
“By extending the vaccination program to everyone who has been offered preventative antibiotics, we are taking an important additional step to protect those most likely to have been exposed. The message is simple: if you have had the antibiotic, you are also eligible for the vaccination,” said Professor Susan Hopkins, Chief Executive of the UKHSA.
However, Trish Mannes, UKHSA Regional Deputy Director for the South East, noted that even after two doses, the MenB vaccine “does not protect against all strains of meningococcal disease, nor against all infections that can cause meningitis. It also does not prevent the bacteria from being carried and spread in the community”.
The UKHSA thus warned people to be aware of the signs and symptoms of invasive meningococcal disease, and to seek immediate medical attention if they or anyone they know develops these signs and symptoms.
Common symptoms include:
- rash
- sudden onset of high fever
- severe and worsening headache
- vomiting and diarrhoea
- joint and muscle pain
- seizures.
© 2024 Bennett, Coleman & Company Limited

